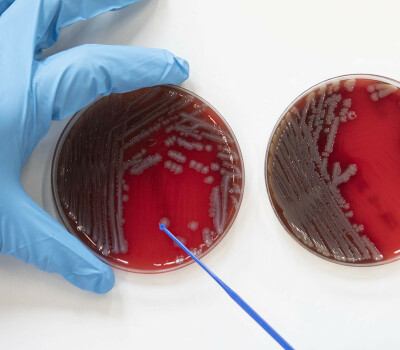

Extrema Outdoor als opstap naar een nieuwe kijk op druggebruik

Afgelopen weekend was het de tiende editie van Extrema Outdoor, voor de eerste keer met een testdorp voor drugs. De middelen die de politie in beslag nam of die de festivalgangers zelf indienden, gingen meteen naar een laboratorium op het terrein. De controle op dosering en kwaliteit was niet zonder resultaat.
De organisatie ontdekte drie gevaarlijke xtc-pillen en waarschuwde de festivalgangers via verschillende kanalen, waaronder schermen op het festivalterrein. Wie de vorm van het “Casa de Papel”-masker, Mario Bros of een schoppenaas herkende, wist dat hij of zij moest oppassen. Deze aanpak is een schoolvoorbeeld van een harm reduction strategie.
Harm reduction omvat alle interventies, programma’s en maatregelen die streven naar het verminderen van de gezondheids-, sociale – en economische schade van druggebruik. Critici omschrijven harm reduction als romantiserend of stimulerend.
Dit is niet correct, blijkt uit verschillende wetenschappelijke studies. Toch wordt in het bredere maatschappelijke debat -en binnen bepaalde hulpverlening- abstinentie (volledig en permanent stoppen met druggebruik) vaak als enige kwaliteitsvolle doelstelling naar voor geschoven. Dit vertaalt zich naar een repressieve aanpak. Zonder het gewenste effect, integendeel.
Druggebruik in opmars
De voorbije jaren werden steeds meer en sterkere middelen makkelijker beschikbaar. De combinatie met de toenemende normalisering van druggebruik in het uitgaansleven heeft het potentieel om schade aan te richten.
Het totale druggebruik ligt erg hoog en hulpverleningsorganisaties zien het aantal aanmeldingen stijgen. Aanwijzingen hiervoor liggen in metingen in het afvalwater door het Europees Waarnemingscentrum voor Drugs en Drugverslaving. Alle middelen die onderzocht worden, op een na, blijken in opmars. Met onder meer een verdrievoudiging van de gemeten waarden voor ‘crystal meth’ tussen 2019 en 2021.
Harm reduction voor, tijdens en na gebruik
Is het daarom geen tijd om het geweer van schouder te veranderen en om meer in te zetten op het beperken van de negatieve impact en minder op abstinentie en repressie? De meeste gebruikers passen al verschillende zelfcontrole strategieën toe om de risico’s te beperken.
Dit doen ze door te letten op de combinatie van middelen, voldoende tijd tussen de dosissen te laten, zich te hydrateren en op tijd te rusten.
Een opstap naar vermindering en onthouding
Deze voorzorgsmaatregelen zorgen er voor dat mensen die drugs gebruiken niet in het ziekenhuis, of erger, belanden. Harm reduction kan bovendien een opstap zijn naar vermindering, of zelfs onthouding van middelengebruik. Dit bewijst dat harm reduction en abstinentie in mekaars verlengde liggen, waarbij abstinentie de ‘ultieme’ vorm van harm reduction is.
Nog te vaak zet de hulpverlening de twee vormen, onterecht, tegenover elkaar. Terwijl het beste resultaat wellicht bereikt zal worden door een gecombineerde aanpak: het inperken van het gebruik en het beperken van de gevolgen.
We kunnen tot slot alleen maar aanmoedigen dat Belgische festivals deze zomer het vooruitstrevende voorbeeld van hun Limburgse en Europese collega’s volgen.
Tom Platteau, Eric Florence, Ludwig Apers, Corinne Herrijgers en Lieselot Ooms zijn verbonden aan het Instituut voor Tropische Geneeskunde (ITG) in Antwerpen. Ze ontwikkelden de gezondheidsapp Budd, die personen helpt om gezonder om te gaan met druggebruik.
Spread the word! Deel dit artikel op